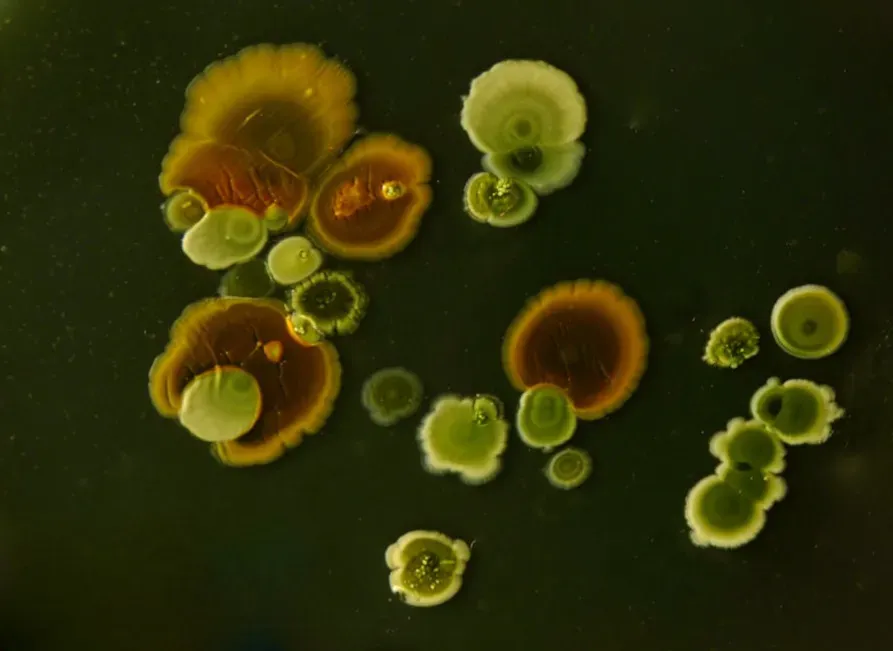
Harnessing Microbes: From Fermentation to Future Tech (Image Credits: Unsplash)

If every plant, animal, and human vanished tomorrow, microbes would barely flinch. But if microbes disappeared instead, the world as we know it would collapse in a matter of days. It sounds dramatic, even a little unsettling, yet it’s the quiet truth behind almost everything that keeps this planet running.
We grow up learning about lions, trees, and whales, but not about the microscopic life that outnumbers every other living thing. These tiny beings have no faces, no voices, and no obvious presence, but they drive the cycles of air, water, soil, health, and even climate. Once you start seeing the world through their lens, it’s hard to look at a forest, an ocean, or even your own body the same way again.
The Invisible Majority: Microbial Life Is Everywhere

Open your hand and imagine more living things on your skin than there are people in many cities. That’s not an exaggeration; it’s daily reality. Microbes are in the air you breathe, the water you drink, your gut, your mouth, your phone screen, and even deep inside rocks thousands of meters below your feet. They live in boiling hot springs, acidic mine drainage, polar ice, and deep-sea vents where no sunlight ever reaches.
What’s truly shocking is their sheer abundance and age. Microbes have been around for more than three billion years, long before animals, plants, or any complex life evolved. In terms of both biomass and genetic diversity, they are the main characters on Earth, and we are more like a recent side story. When we talk about “life on Earth,” we’re mostly talking about microbial life, even if we rarely realize it.
Microbial Architects of the Atmosphere

The air you’re breathing right now carries a signature written by microbes billions of years ago. Early microbial life, particularly cyanobacteria, transformed Earth’s atmosphere by producing oxygen through photosynthesis. Before that, our planet was essentially unbreathable for animals like us. Microbes literally made the sky hospitable, reshaping oceans, rocks, and even the chemistry of the entire planet.
They still play that role today. Marine microbes in the surface ocean pump out a huge portion of the world’s oxygen supply and help pull carbon dioxide out of the atmosphere. Tiny plankton and bacteria act like a global thermostat, influencing climate patterns and carbon storage. When we talk about climate change and carbon emissions, we’re also, quietly, talking about how we’re disturbing ancient microbial feedback systems.
The Planet’s Recycling System: Microbes and Nutrient Cycles

If microbes took a day off, dead leaves would pile up, animal remains would linger, and waste would just… stay. Microbes are the planet’s cleanup crew, breaking down organic matter into simpler molecules. They convert what’s dead back into forms that plants, fungi, and animals can use again, keeping nutrients like carbon, nitrogen, and phosphorus moving through soils and water.
They also drive critical chemical loops that rarely make headlines. Certain bacteria can “fix” nitrogen from the air into a form plants can absorb, which is essential for crops and wild ecosystems. Others release nutrients locked in rock or detritus, slowly feeding forests, grasslands, and oceans. Without this invisible recycling network, Earth would be cluttered with unrotted remains and starved of usable nutrients, like a city where the garbage trucks never come.
Microbes in Our Bodies: Friends, Foes, and Everything Between

Your body is not just you; it’s an ecosystem. Trillions of microbes live in your gut, on your skin, in your mouth, and even in the tiny folds of your eyelashes. Collectively, they form your microbiome, and they’re deeply woven into digestion, immunity, metabolism, and even how you respond to certain medications. In a sense, you’re more like a walking microbial habitat than a single, isolated organism.
Of course, some microbes do cause disease, and that’s usually where the spotlight lands. But the majority are neutral or beneficial, helping break down food, producing vitamins, training your immune system, and crowding out more dangerous species. When we disrupt this community with poor diet, chronic stress, or overuse of antibiotics, things can spiral into inflammation, gut disorders, and other health issues. It’s a strange feeling to realize that caring for yourself also means caring for your inner microbial neighbors.
Microbes as Earth’s Oldest Innovators

Microbes also swap genes with a freedom that would make any engineer jealous. Instead of waiting for slow evolution, they can trade genetic tricks like USB drives, picking up antibiotic resistance or new metabolic tools from their neighbors. This flexibility helps them survive environmental shocks and colonize new niches quickly. In many ways, microbes are the ultimate innovators, constantly rewriting the rules of what life can do.
Harnessing Microbes: From Fermentation to Future Tech
Humans have been teaming up with microbes for a very long time, even before we knew they existed. Bread, cheese, yogurt, beer, wine, soy sauce, sauerkraut, kimchi, and countless other foods rely on microbial fermentation. Those bubbles in bread and the tang in yogurt are the work of yeast and bacteria doing their thing, transforming simple ingredients into something safer, tastier, and often more nutritious.
Today, that partnership is getting far more sophisticated. Scientists are engineering microbes to produce medicines, biodegradable plastics, biofuels, and even lab-grown materials like spider-silk-like fibers. Wastewater treatment, bioremediation of oil spills, and pollution cleanup also depend heavily on microbial processes. When people talk about the future of sustainable technology, a lot of that future is microscopic.
Microbes, Climate, and the Planet’s Future

Microbes sit at the center of the climate story, whether we notice them or not. In thawing Arctic permafrost, microbes wake up and start breaking down long-frozen organic matter, releasing carbon dioxide and methane into the atmosphere. In oceans, warming waters change which microbial communities thrive, potentially disrupting food webs and reducing the ocean’s ability to store carbon. These shifts can amplify or dampen climate change in ways scientists are still racing to understand.
There’s also a hopeful side. Microbes are being studied for carbon capture, soil restoration, and even helping crops tolerate heat and drought. Some researchers are exploring how to nudge microbial communities to lock more carbon into soils or ocean sediments. The uncomfortable truth is that we’ve unintentionally been pushing microbial systems off balance for decades, but we might also work with them to help bend the planet back toward stability.
A Hidden Kingdom We Can No Longer Ignore

Once you realize microbes rule the world, the familiar landscape changes. A forest becomes a layered network of roots and fungal threads, coated with bacteria that help plants feed and communicate. A handful of soil turns into a crowded city of microscopic life, all trading nutrients, signals, and energy. Even a glass of tap water or a breath of air feels less empty and more alive.
We tend to care most about what we can see, but the real foundation of our planet is almost entirely invisible. Microbes created the conditions for complex life, sustain the cycles that feed us, and influence our health in ways we’re only beginning to grasp. Paying attention to them is not just fascinating; it’s necessary for understanding where we came from and where we’re going. When you look around now, do you still feel alone on the surface of the world, or can you sense the hidden kingdom humming beneath everything?



